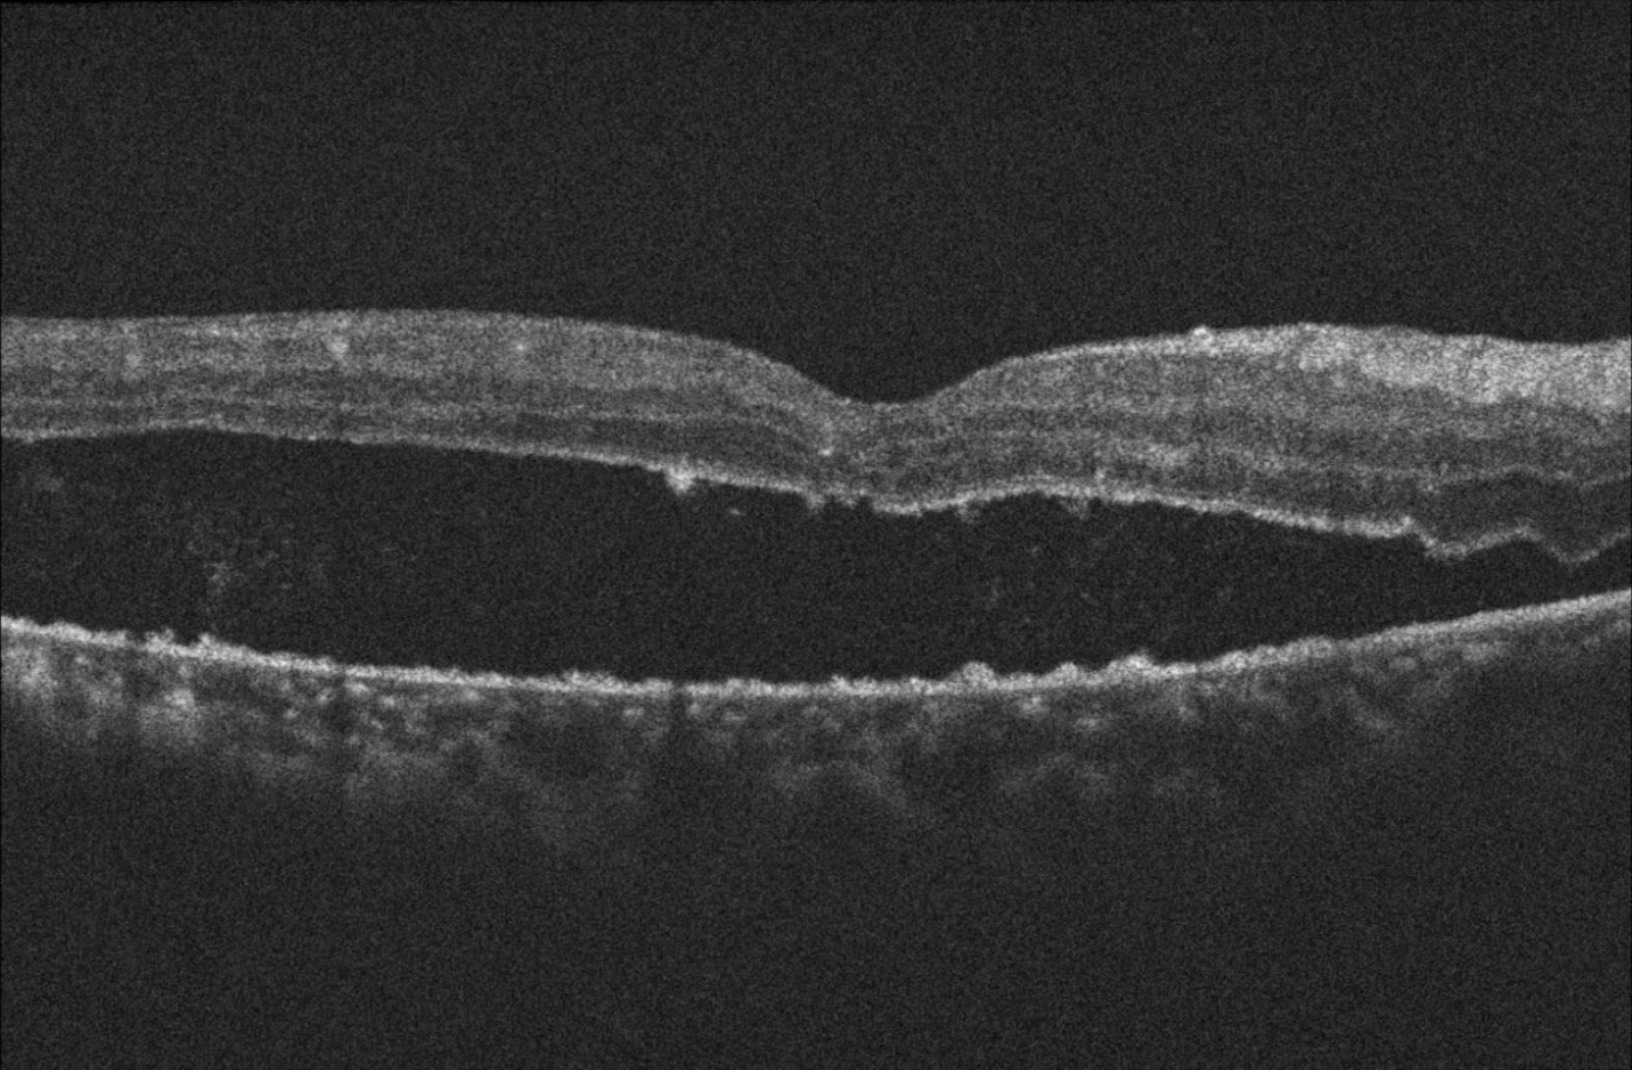

Resumen
| Clasificación | Color | FAG | OCT | USG Modo B | Capilares | Tratamiento | Qué buscar |
|---|---|---|---|---|---|---|---|
| Sin RD | ![]() | ![]() | ![]() | ![]() | ![]() ![]() ![]() | Ejercicio Dieta Medicamento | Disminución perfusión plexo superficial en OCTa |
| RDNP Leve | ![]() | ![]() | ![]() | Normal | ![]() | Revisión anual | Microaneurismas Microhemorragias |
| RDNP Moderada | ![]() | ![]() | Normal o EMD | Normal | ![]() | Revisión 3-6 meses | Exudados |
| RDNP Severa | ![]() | ![]() | Normal o EMD | Normal o engrosamiento coroideo | ![]() | Revisión mensual LASER (?) | MA y MH 4C IRMA 2C Rosario 1C |
| RDP | ![]() | ![]() | Normal o EMD | Normal o engrosamiento coroideo | ![]() | LASER | Neovasos |
| RDP HV o HS | ![]() ![]() ![]() | ![]() ![]() ![]() | Normal o EMD | Normal o engrosamiento coroideo | ![]() | CIRUGIA: Vitrectomía + Endolaser | H Vítrea H Subhialoidea |
| RDP DRT | ![]() | ![]() | ![]() | ![]() | CIRUGIA: Vitrectomía + Endolaser + Silicón | Tracción sobre todo macular | |
| GNV | ![]() | Cualquiera de los anteriores | Normal o EMD | Normal o engrosamiento coroideo | ![]() | CIRUGIA: Vitrectomía + Endolaser + Silicón + Válvula | TIO muy elevada |
| Consumada | Cualquiera de los anteriores | Normal o EMD | Normal o engrosamiento coroideo | ![]() | Paliativos y tratamiento del dolor en caso necesario | Visión NPL | |
| Edema macular | ![]() | | ![]() | ![]() | Anti-VEGF Triamcinolona Dexametasona | Engrosamiento macular |
<<<<<<<<<<<<<<<<<<<<<<<<<<<<<<<<<<<<<<<<<<<<<<<<<<<<<<<<<<<<<<<<<<<<<<<<<<<<<<<<<<<<<<<<<<<<<<<<<<< EDEMA MACULAR >>>>>>>>>>>>>>>>>>>>>>>>>>>>>>>>>>>>>>>>>>>>>>>>>>>>>>>>>>>>>>>>>>>>>>>>>>>>>>>>>>>>>>>>>>>>>>>>>>>>>>
Última actualización: 2025-10-25 01:22:25







Disminución perfusión plexo superficial en OCTa